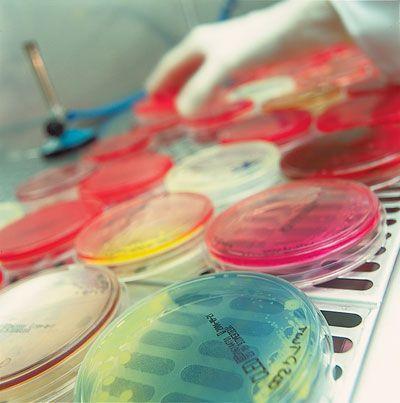
microlabdr's profile picture. MICROLAB DOMINICANA SRL,
Es un laboratorio de análisis microbiológico para agua y alimentos, ofrecemos consultorias y capacitaciones en: Inocuidad, HACCP, etc.

#microlab search results

La construcción de un nuevo pacto social se realizará con la participación de toda la población para afrontar sus realidades. #MicroLAB #XiomaraPresidenta
با اشتغال مستقيم ٣٠٠ نفره مجموعه در آستانه ي ٣٣ سالگى تاسيسش شوآف بكنم يا زوده ؟!؟ #microlab #ميكرولب @microlab_iran

Thank you very much #microlab for joining me in the celebration of #WorldDiabetesDay. #Diabetesclinic loading at #CHUK. I love what I do.

Students from @CVESD_Olympic collaborate to each have a VOICE using the #MicroLab protocol. Creative thinking —> solutions! #ESLearns
La migración forzada en los últimos 12 años ha sido parte del fracaso del P. Nacional en administrar un govierno al servicio del pueblo, por lo tanto, este #28N #VotaTodoLibre para garantizar la salida de aquellos que no defienden la vida del hondureño/a #MicroLAB @XiomaraCastroZ
We are growing writers! Coaching Wagon Wheel in action today. #microlab #writingconferences @RachelLawsontx @lauriwa59033040 @HasletElem @MancinoTara @TCRWP


El gobierno de @XiomaraCastroZ transformará el sistema educativo del país. #VotaTodoLibre para garantizar que se aprueben los presupuestos necesarios para fortalecer nuestra educación. #MicroLab #SeVan #XiomaraPresidenta
Lequel choisir ? Les couleurs sont juste parfaites, bien raccord avec @LesSondiers ! Merci @ArturiaOfficial pour les #microlab, on ne savait pas que vous nous aimiez tant que ça ! 😉

I’m always surprised at what you can get with a microscope, a steady hand, and an iPhone camera. Here’s a beautiful CMV DFA from BWH Micro lab. #IDtwitter #microlab #microrounds @AnotherSun13

DID ARTURIA JUST ANNOUNCE A NEW KEYSTEP? no 😔. Despite my endless tweets demanding a Keystep Pro version, we get this “thing.” Introducing the #microlab , possibly the most boring controller ever made. If my dad was the CEO of Arturia he would have come out with this Microlab.
🚨 Ce mardi on prend de la hauteur dans @MicroLaboff ! Ne manquez pas la première ! 🚨 @SpaceX , be prepared ! #MicroLab
🗣️ La première émission MicroLab sera diffusée mardi 29/09 à 14h sur @campusgrenoble, 90.8 🔜 On vous attend nombreuses et nombreux pour discuter ensemble de l'entreprise SpaceX en compagnie des membres d'@AurorAlpes 🌕🎙️
En #Microlab, nos fijamos mucho en los detalles. Concretamente en los detalles microscópicos de las muestras que hemos recogido estos días #ekids18



The Arturia MicroLab is the Highest Rated MIDI Keyboard Controller Under $100: gearank.com/guides/cheap-m… @ArturiaOfficial #Arturia #MicroLab #ArturiaMicroLab #CheapMIDIKeyboard #MIDIKeyboard #MIDIKeyboards #MIDIKeyboardController #MIDIGear #MusicGear

Just under a month to go until #Microlab & #Prague #Microfestival 13-27 October @ Sklep E, Kampus Hybernská watch this space!

Back to the studio ! 🔥🔥🔥 Today, having fun with the @ArturiaOfficial Keylab 61 MK2 + Microlab ! DAW : Ableton PLUGINS : Arturia Analog Lab v4 + Pigments Arturia 7.1 youtu.be/XJ0-xYVBXFM #RESOURCE #LIMITEDRESOURCE #microlab #arturia #keylab
Microlab TMN1 2.1 Multimedia Speaker — built for those who want rich, powerful sound without the gimmicks. 🔥 Available now at TBZ Engineering 📞 Contact us today: +880 1718144944 / +880 1713991638 #Microlab #TMN1 #MultimediaSpeaker #MusicLovers #SoundSystem #TBZengineering

Power meets clarity with the Microlab M108BT Bluetooth 2.1 Speaker. Deep bass, crisp highs, and wireless freedom — made for pure listening pleasure. 🔥 Available now at TBZ Engineering #Microlab #BluetoothSpeaker #DeepBass #TBZEngineering

Microlab Mogul Headphone(Brown) ShareMe: Support connecting to two Bluetooth devices Bluetooth Streaming: Stream music,or make calls from your devices 3.5mm audio line-in function ৳ 8,100.00 computersquadronbd.com #computer_squadron #headphones #Microlab #elephont_road #CSBD

🔬 #MicroLAB – The Microelectronics Research Group of National Technical University of Athens, a leading research lab driving advancements in microelectronics, VLSI design, and integrated circuits, contributing to Greece’s semiconductor innovation landscape.
แย่ว่ะลำโพงคอมพิวเตอร์กูเสีย เสียงออกข้างเดียว ก็เลยว่าจะซื้อลำโพงใหม่ ที่เล็งๆอยู่ก็มีของ #MICROLAB X2 รอให้เบี้ยเลี้ยงกูออกก่อนเหอะ ตอนนี้ไม่มีเงิน จะทำอะไรมันดูติดขัดไปหมด ดีที่แม่ครัวบ้านกูเค้าให้กูยืมพันนึง เป็นค่าบุหรี่ แต่กูไม่เอาเปรียบเค้านะ ยืม 5 วันกูให้ดอกเบี้ย 100นึง/

Elogio del colaje (tributo) por @empleopositivo #Microlab #Colaje ratonlab.wordpress.com/2025/10/04/elo…
Laboratorio vinculado (devolución) por @empleopositivo #Microlab #Devolución ratonlab.wordpress.com/2025/09/26/lab…
ratonlab.wordpress.com
Laboratorio vinculado (devolución)
El curso-experimento de Diseño Cívico organizado Domenico Di Siena se puede aplicar fácilmente a un proyecto de blog-tertulia vinculado a una plaza de un barrio o pueblo. Sin embargo, Ratonlab es u…
RF Industries' new red plenum-rated jumpers are ideal for public safety applications. They are low PIM, CMP UL-listed, and feature minimal RF insertion loss. Shop now at Talley: ow.ly/E0eH50WXFRG #Microlab #RFI #LMR

Ratonlab: heterónimo cívico por @empleopositivo #Microlab #Heterónimo ratonlab.wordpress.com/ratonlab-heter…
ratonlab.wordpress.com
Ratonlab: heterónimo cívico
Retomé este blog-laboratorio en agosto ’25 con el curso-experimento de Diseño Cívico con IA de Domenico Di Siena. Hasta ahora, la única formación que tenía era el Curso ’21 de LABBBS. D…
“Part 2: Selectra Clinical Chemistry – High Performance, Low Maintenance, Perfect for Our Region.” #AMSSUganda #MicroLab #SelectraClinicalChemistry #DiagnosticSolutionsAfrica #LabTechnology
#Microlab #A6331 microlab.com/ru/catalog/sny… ・内部点検、端子クリーニング、マスターボリュームのクリーニング ・サウンドテスト(左右バランス、サブウーハー調整) #ロシア製

Public investment in a microfabric lab trains weavers on natural-fiber processing, generating pandanus yarn for exclusive fashion lines. #MicroLab #Fiber Online e-commerce portal for Niue designs launched in 2024, enabling international orders and streamlined shipping logistics.
Nie masz dużo miejsca na biurku? @ArturiaOfficial #MicroLab Mk3 to ultra-kompaktowa klawiatura MIDI, która kosztuje mniej niż przeciętny kabel gitarowy premium. Ale czy jest przydatna dla gitarzysty lub bedroom-producenta? Sprawdzamy to dla Was! uptone.pl/pianosynth/czy…

Na een week hard werk is het tijd voor ontspanning, Microlab | (Flex)kantoren, maker space, evenementen & coworking Summer BBQ🥂🍖 #5050Recruitment #Microlab #Rotterdambuilding #Havingfun #Bigfamily #Networking #Trending #SummerVibes



Na werk gezellig met mooi weer een wijnproeverij gehad op het dakterras van Microlab met @Ishan5050 @IlLibanese1975 en Ayke morgen weer! 🍷 ☀️ #5050Recruitment #Recruitment #Microlab #Dakterras #Gezelligheid #Werkplezier #Trending #GoodVibes #AltijdAan #PeopleFirst…

Сделал неплохой эквалайзер для своих колонок от #Microlab, под #Spotify. Не идеально, но я работаю над этим xD #music #equalizer #rock #bass #pop #edm #electronic

😍パワーレック新製品情報! ikebe-gakki.com/Form/Product/P… ikebe-gakki.com/Form/Product/P… 新登場❣Arturia MICROLAB MK3はクラス最高峰のキータッチ、頑丈なボディ、そして最新のUSB-C接続で、どんな場所でもすぐに音楽制作を始められます。 #arturia #MICROLAB


2/3 MicroLab mk3 wyposażono w port USB typu C i wejście dla kontrolera nożnego, a tak jak poprzednia wersja oferuje oferuje 25 mini-klawiszy, dotykowe kontrolery Pitch Bend i Modulation oraz cztery przyciski funkcyjne. #Arturia #MicroLab #MicroLabmk3

Karnival Mikrobiologi 2018 bersama adik-adik comel sekitar Bangi & Putrajaya. #letexplore #microlab #fstukm #ukm #ukmsharing





The power of #MicroLab protocol #LookingForLearning with @carlamarschall. 🙏🏻 #TeacherGrowth #ReflectivePractice #EffectivePlanning @BBISlearning


Thank you very much #microlab for joining me in the celebration of #WorldDiabetesDay. #Diabetesclinic loading at #CHUK. I love what I do.

We are growing writers! Coaching Wagon Wheel in action today. #microlab #writingconferences @RachelLawsontx @lauriwa59033040 @HasletElem @MancinoTara @TCRWP


🏆🏆 🏅🏅The nerdy derby project got the #MakerOfMerit award at @EHVMMF 2018 🏆🏆 in co-production with #microlab #sintlucas #thanks again




Lequel choisir ? Les couleurs sont juste parfaites, bien raccord avec @LesSondiers ! Merci @ArturiaOfficial pour les #microlab, on ne savait pas que vous nous aimiez tant que ça ! 😉

🚨 Ce mardi on prend de la hauteur dans @MicroLaboff ! Ne manquez pas la première ! 🚨 @SpaceX , be prepared ! #MicroLab
🗣️ La première émission MicroLab sera diffusée mardi 29/09 à 14h sur @campusgrenoble, 90.8 🔜 On vous attend nombreuses et nombreux pour discuter ensemble de l'entreprise SpaceX en compagnie des membres d'@AurorAlpes 🌕🎙️
Na inleiding @MarietjeSchaake nu panel #SmartSociety meets #Design @dutchdesignweek @VNGRealisatie #Microlab @StrijpS over #data #AI #design #DigitaleSpelregels #smartmobility #innovatie #technology #inclusief


En #Microlab, nos fijamos mucho en los detalles. Concretamente en los detalles microscópicos de las muestras que hemos recogido estos días #ekids18



Thinking routines help us process, explore, and expand on concepts. ESP+1 had us digging into life at the California missions. #Hansen4th used #EvidentialReasoning & then #MicroLab to share their interpretations. #SycRidge #DMUSD @RonRitchhart



با اشتغال مستقيم ٣٠٠ نفره مجموعه در آستانه ي ٣٣ سالگى تاسيسش شوآف بكنم يا زوده ؟!؟ #microlab #ميكرولب @microlab_iran

✨🎁✨ Bu ay 1 kişiye yüksek kaliteli tuş takımına sahip akıllı bir 25 tuş controller @ArturiaOfficial #MicroLab hediye ediyoruz!😲

First presentation as a resident ✅ It was memorable!!! 🤩 A special thanks to @MilkisDmitriy and husband! #pathology #microlab #PathTwitter #residentlife @NorthwellHealth @ZuckerSoM



Something went wrong.
Something went wrong.
United States Trends
- 1. Steph 49.3K posts
- 2. Wemby 23.2K posts
- 3. Spurs 25.8K posts
- 4. Draymond 8,602 posts
- 5. Clemson 10.7K posts
- 6. Louisville 10.6K posts
- 7. #SmackDown 47.8K posts
- 8. Zack Ryder 14.5K posts
- 9. Aaron Fox 1,628 posts
- 10. #DubNation 1,742 posts
- 11. Dabo 1,925 posts
- 12. Harden 11.7K posts
- 13. Brohm 1,525 posts
- 14. Landry Shamet 5,420 posts
- 15. #OPLive 2,417 posts
- 16. Matt Cardona 2,679 posts
- 17. Marjorie Taylor Greene 39.4K posts
- 18. Miller Moss N/A
- 19. UCLA 7,918 posts
- 20. #CLAWMARK3D 36.7K posts